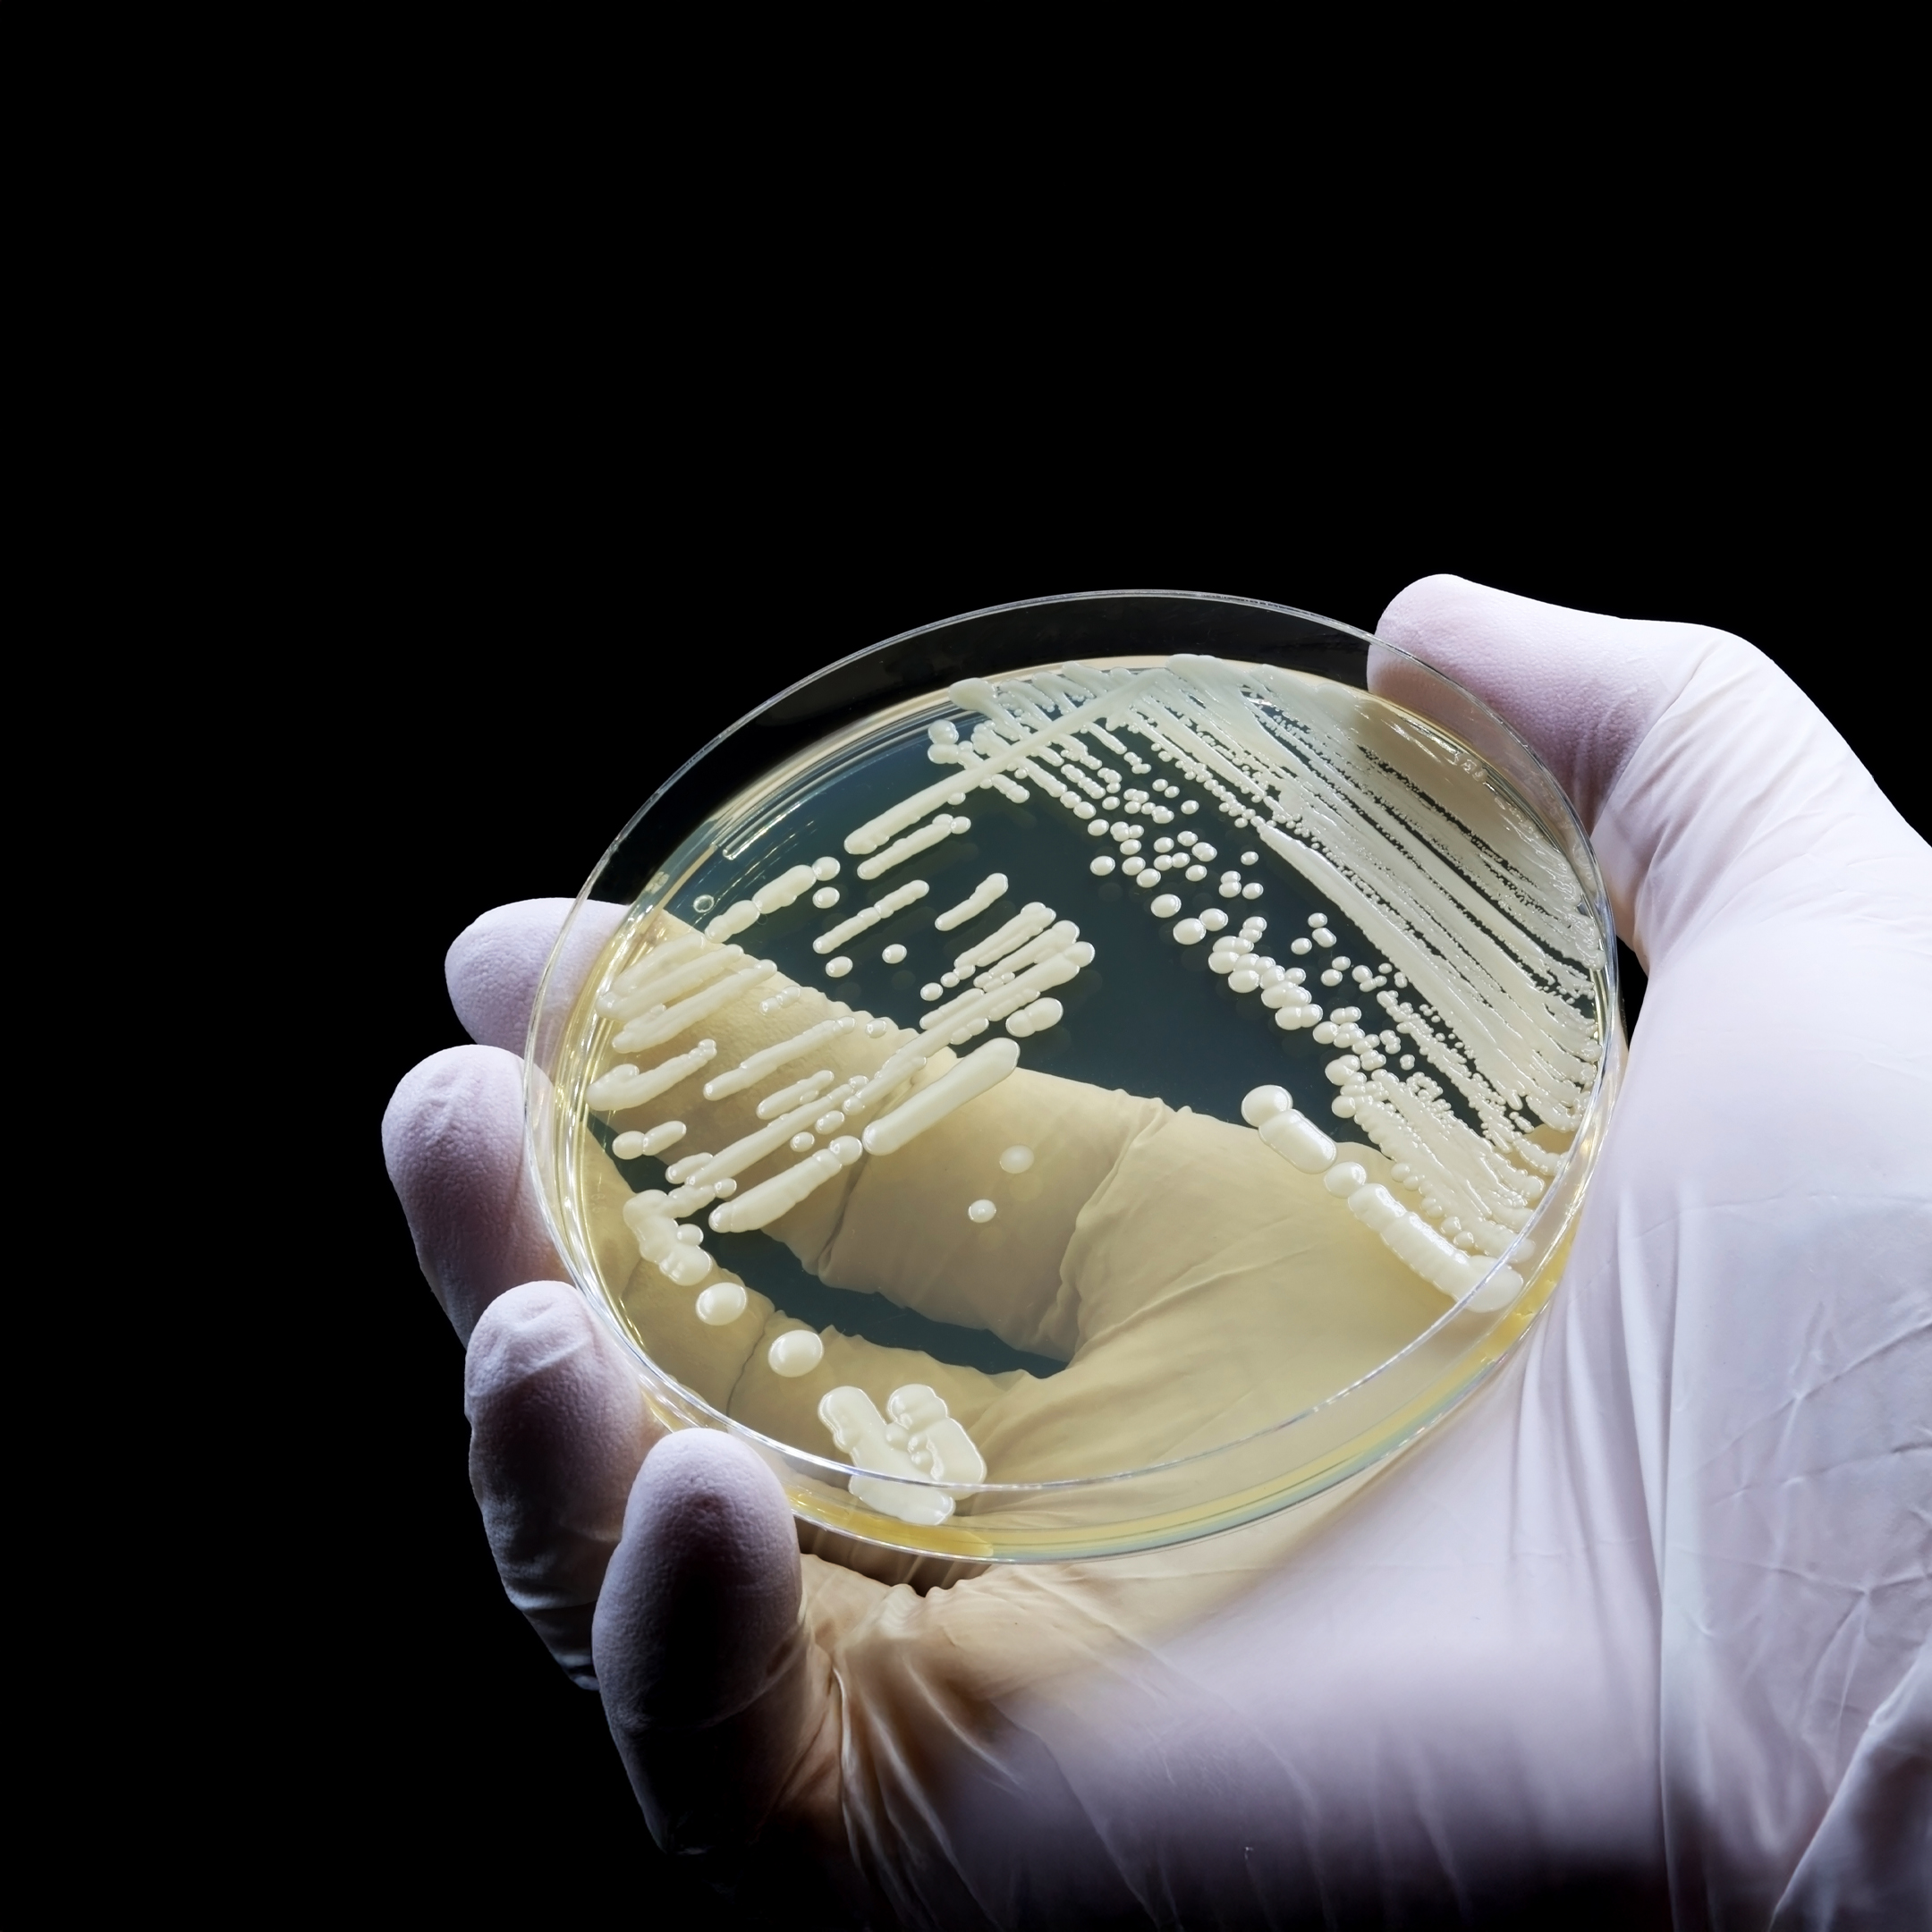
kvasinka

BrainMax VitaCholine® & Inositol, 100 db növényi kapszula Mio-inozitol a nők hormonális egyensúlyának támogatására, 100 adag, étrend-kiegészítő
Kód: 66453Kapcsolódó termékek
Termék részletes leírása
Elsőrangú neuron táplálás és a psziché támogatása3!
Prémium kombináció, amely célzottan támogatja az idegrendszer optimális működését és a pszichés tevékenységeket a B6-vitamin aktív P-5-P formájának köszönhetően. Természetes VitaCholine® kolinnal és mio-inozitollal együtt ideális szinergikus triót alkotnak a legigényesebb szükségletek kielégítésére nemcsak az agy és neuronok, hanem a test számára is.

Amikor a forma számít – VITACholine®
A szokványos kolin formákkal szemben (pl. szintetikus kolin bitartrát), a VITACholine® egy ultratiszta kolin forma, amelyet szabadalmaztatott eljárással gyártanak az USA-ban. Jellemzői a magas stabilitás, kiváló felszívódás és minimális mellékanyagok. A Balchem gyártó a világ vezetője a kolin vegyületek terén, és biztosítja a GMO-mentes és szintetikus színezékektől mentes tisztaságot. Ezt a formát használták a Cornell Egyetem (Charlotte Bahnfleth) hosszú távú kutatásában, amely a leendő anyák kiegészítésére összpontosított.4
%20-%202025-07-10T130924.496.jpg)

Hogyan működik a kolin és inozitol a testben?
BrainMax VitaCholine® & Inositol egy étrend-kiegészítő, amely szabadalmaztatott VitaCholine® formájú kolint tartalmaz, amelyet természetes forrásokból (élesztő) fermentálással nyernek, valamint inozitolt.
A VitaCholine® a test számára természetes, nagy biológiai hozzáférhetőséggel rendelkező kolin forma, amely az acetilkolin prekurzora – ez a neurotranszmitter fontos az idegi impulzusok továbbításához.
A termék B6-vitamint is tartalmaz, amely hozzájárul az idegrendszer normális működéséhez, a pszichés tevékenységekhez és a fáradtság csökkentéséhez. Ajánlott fokozott fizikai vagy szellemi megterhelés esetén is.
Hogyan járul hozzá a kolin a máj egészségéhez és a zsírok anyagcseréjéhez? A kolin természetes része a foszfolipideknek, amelyek a sejtmembránokat alkotják és lehetővé teszik a zsírok megfelelő szállítását a májból.
Nem minden kolin egyforma
A VitaCholine® egy prémium, klinikailag tesztelt kolinforma, amelyet fermentálással állítanak elő – nem olcsó szintetikus anyag, hanem a test számára természetes és nagy biológiai hozzáférhetőséggel rendelkező forma. Egyedülállóként Csehországban használjuk ezt a szabadalmaztatott anyagot, amely megfelel a legszigorúbb tisztasági és minőségi szabványoknak. A szokványos kolin bitartráttal összehasonlítva a VitaCholine® jobb felszívódást és hatékonyságot kínál a szervezet felesleges terhelése nélkül.
%20(3).jpg)
Hogyan kapcsolódik a kolin és inozitol a lelki jólléthez?
A B6-vitamin hozzájárul a normális pszichés tevékenységhez3, ami kulcsfontosságú különösen azokban az időszakokban, amikor túl sok minden van a vállunkon. A kolin az acetilkolin prekurzora – neurotranszmitter, amely természetesen részt vesz az idegi átvitelben. A mio-inozitol természetesen előfordul a testben, és számos biológiai folyamat része, beleértve az ideg- és reproduktív rendszerekkel kapcsolatosakat. A B6-vitamin hozzájárul a normális pszichés tevékenységhez és az idegrendszer működéséhez3. A kolinnal és mio-inozitollal kombinálva szinergiát alkotnak, amely fontos a metabolikus folyamatok3,1 és az idegrendszer normális működése számára.3
Amikor a test nem tud miből építkezni
A kolin közvetlen prekurzora az acetilkolinnak – anyagnak, amely szerepet játszik az ideg-izom átvitelben. Magasabb fizikai igénybevételnél a test több kolint fogyaszt, de gyakran nem képes azt magától pótolni. És amikor nincs miből építkezni, a regeneráció és az izomműködés egyszerűen lelassul. A VitaCholine® egy szabadalmaztatott kolinforma kiváló felszívódással, amelyet nemcsak az agy, hanem a mozgásban lévő test is értékel.

%20(32).png)
Miért fontos a kolin?
A kolin esszenciális tápanyag, amely természetesen elsősorban állati eredetű élelmiszerekben található meg (tojás, máj). A test bár képes részben előállítani, a legtöbb mennyiséget táplálkozással vagy kiegészítőkkel kell bevinni. Ennek ellenére gyakran figyelmen kívül hagyják, mert nem tartozik hivatalosan a B-vitaminok közé.
Inozitol – a B-vitaminokhoz közeli anyag
Az inozitol (különösen mio-inozitol formában) gyakran megtalálható olyan étrend-kiegészítőkben, amelyeket hormonális változások időszakában keresnek nők.
Hol található kolin az élelmiszerekben?
A kolin nagyon hasonló a B-vitaminok csoportjához, és megtalálható a mindennapi ételekben, különösen azokban, amelyek gazdagok zsírokban és fehérjékben. A leggazdagabb források közé tartozik a tojás és a máj, de kolin található lazacban, brokkoliban, szójában és tejtermékekben is. Miért lehet azonban alacsony a bevitel? Elsősorban a megnövekedett igények miatt, például terhesség alatt, belső feszültség vagy fizikai megterhelés esetén, amikor a test nem képes elegendő mennyiségben felvenni. Vegánok és vegetáriánusok esetében a kolinbevitel még alacsonyabb.
%20-%202025-07-10T120925.132.jpg)
Kolin a napi bevitel részeként
Ahhoz, hogy egy felnőtt férfi elérje az ajánlott napi 550 mg kolin bevitelét, például napi 4 tojást vagy több mint 100 g marhamájat kellene ennie – ezért a kolin kiegészítése étrend-kiegészítő formájában is megfelelő.
Ajánlott napi kolinbevitel (EFSA):
- Felnőtt férfi: 550 mg/nap
- Felnőtt nő: 425 mg/nap
- Terhes nő: 450–930 mg/nap
A BrainMax VitaCholine® & Inositol termék egy kapszulája 625 mg kolin bitartrátot tartalmaz, ami 250 mg elemi kolinnak felel meg – alkalmas a napi bevitel részeként.
%20-%202025-08-06T100851.720.jpg)

Kinek ajánlott a termék?
- Terhes és szoptató nők, akiknek megnövekedett a kolin igénye. A kolin alapvető szerepet játszik a magzat agyának fejlődésében és az idegcső megfelelő fejlődésében. Az Európai Élelmiszerbiztonsági Hatóság (EFSA) szerint a terhes nők napi ajánlott kolinbevétele 480 mg/nap, míg a szoptató nőké akár 520 mg/nap.¹ A BrainMax VitaCholine egy kapszulája 625 mg kolin bitartrátot tartalmaz (ami 250 mg elemi kolinnak felel meg), így könnyen beilleszthető a napi bevitelbe.
- Egysíkú vagy növényi alapú étrendet követők, ahol a kolin (amely általában állati termékekben található) kevésbé fordulhat elő.
- Magasabb pszichés vagy kognitív terhelés alatt állók, mivel a kolin az acetilkolin prekurzora – neurotranszmitter, amely fontos a memória, tanulás és koncentráció szempontjából. Magasabb acetilkolin fogyasztás figyelhető meg, amikor sok feladatunk van, nyomás alatt dolgozunk és nem tudjuk, hol áll a fejünk.
- Mindenki, aki támogatni szeretné a máj működését, különösen ha hosszú távon több zsírt vagy alkoholt fogyaszt, mivel a kolin hozzájárul a lipid anyagcseréhez és a máj megfelelő működéséhez.
- Alkohol fogyasztása esetén – az alkohol növeli a kolin iránti igényt.
- Genetikai polimorfizmusok esetén (pl. MTHFR, PEMT) – a test korlátozottan képes kolint előállítani.
Milyen szerepet játszik a kolin a máj normális működésében?
A kolin a test számára természetes anyag, amely hozzájárul a máj normális működésének és a zsírok anyagcseréjének fenntartásához1. Ugyanakkor részt vesz a homocisztein megfelelő anyagcseréjében1 – egy olyan anyagé, amelynek feleslege nem kívánatos lehet a szervezetben. A VitaCholine® egy szabadalmaztatott, magas tisztaságú kolinforma, amely maximális biológiai hozzáférhetőséget és kiváló minőséget kínál, amelynek köszönhetően a test hatékonyan tud dolgozni a kolinnal.


Milyen más termékekkel használható a kolin
- Koffein - ajánljuk, hogy zöld teából vagy guaranából származó koffeint fogyasszon. Ha mégis kávékedvelő vagy, próbáld ki a hozzáadott értékű kávét - gombákkal.
- L - Theanin - amikor szüksége van egy kis megnyugvásra, az L-Theanin ideális választás. És a koncentráció során a belső nyugalom rendkívül fontos.
- Omega 3 zsírsavak - a DHA az agy sejthártyáinak fő összetevője. Kolinnal kombinálva szuper kombinációt hoz létre.
- Rhodiola rosea - kedvelt adaptogén, amely hatásaival kiválóan kiegészíti a kolint.
- B-komplex – A B-vitaminok, különösen a B6, B9 (folsav) és B12, együtt dolgoznak a kolinnal a homocisztein anyagcseréjében1,3 és támogatják az idegrendszer megfelelő működését.3
- Multivitamin – Segít kiegészíteni más kulcsfontosságú mikrotápanyagokat, amelyek részt vesznek az energia anyagcserében és az általános vitalitásban, így a kolin még hatékonyabb eszközzé válik az agy és a test számára.
- Prenatal complex – Terhesség alatt a kolin iránti igény magasabb az agy és a magzat idegcsövének fejlődése miatt, ezért ajánlott kombinálni egy kifejezetten terhes nőknek szánt komplexszel, amely folsavat és vasat is tartalmaz.

Tanulmányok által igazolt!
Bahnfleth, C. L., Strupp, B. J., Caudill, M. A., & Canfield, R. L. (2021). A prenatális kolin kiegészítés javítja a gyermek hosszan tartó figyelmét: Egy 7 éves követéses randomizált kontrollált etetési vizsgálat. The FASEB Journal.4
Qinhong Huang, Canming Liao, Fan Ge, Jian Ao, Ting Liu. (2022). Az acetilkolin kétirányúan szabályozza a tanulást és a memóriát, Journal of Neurorestoratology.
Derbyshire E, Obeid R. (2020). Kolin, neurológiai fejlődés és agyfunkció: Szisztematikus áttekintés az első 1000 napra összpontosítva. Nutrients.
Adagolás
2 kapszula naponta

A vásárlással támogatod erdőket
| Összetevők | Mennyiség 2 kapszulában | %NRV* |
|---|---|---|
| Természetes kolin VitaCholine® (mint L-bitartát élesztőből) | 1250 mg | ** |
| – ebből kolin | 500 mg | ** |
| Mio-inozitol | 300 mg | ** |
| B6-vitamin (piridoxál-5-foszfát) | 2,6 mg | 186 % |
| * Referencia beviteli érték. ** Referencia beviteli érték nincs meghatározva. |
||
VitaCholine® a Balchem Corporation vagy leányvállalatai védjegye, és az USA-ban, az EU-ban és más országokban is be van jegyezve.
Legenda: Kolin1, Inozitol2, B6-vitamin3
Adagolás: 2 kapszula naponta.
Összetétel adagonként (2 kapszula): természetes kolin VitaCholine® (mint L-bitartát fermentációval nyert élesztőből) (1250 mg, RHP **), ebből kolin (500 mg, RHP **), Mio-Inozitol (300 mg, RHP **), B6-vitamin (mint piridoxál-5-foszfát) (2,6 mg, RHP* 186 %). Növényi kapszula HPMC alapon. Adalékanyagok nélküli.
Tárolás: Szobahőmérsékleten, száraz és sötét helyen.
Figyelmeztetés: Gyermekektől elzárva tartandó! Ne lépje túl az ajánlott napi adagot. Az étrend-kiegészítő nem helyettesíti a változatos étrendet. Tartsa be az egészséges életmódot.
Minimális eltarthatóság/tételszám: lásd a címkén.
Súly: 85,7 g. A csomag 50 adagot tartalmaz.
Forgalmazó: BRAINMARKET s.r.o., Hladnovská 83, Ostrava 712 00, Csehország.
Kiegészítő paraméterek
| Kategória: | BrainMax® |
|---|---|
| EAN vonalkód: | 8595726815035 |
| Csomag mérete: | 100 db növény kapszula |
| Egyének megoldására: | Zdraví mozku, Kognitivní výkon, Psychickou kondici, Idegrendszer, Mozek |
| Forma: | Kapszula |
| Gyártó: | BrainMax |
| Kapszulák száma: | 100 |
Legyen az első, aki véleményt ír ehhez a tételhez!
Legyen az első, aki véleményt ír ehhez a tételhez!


